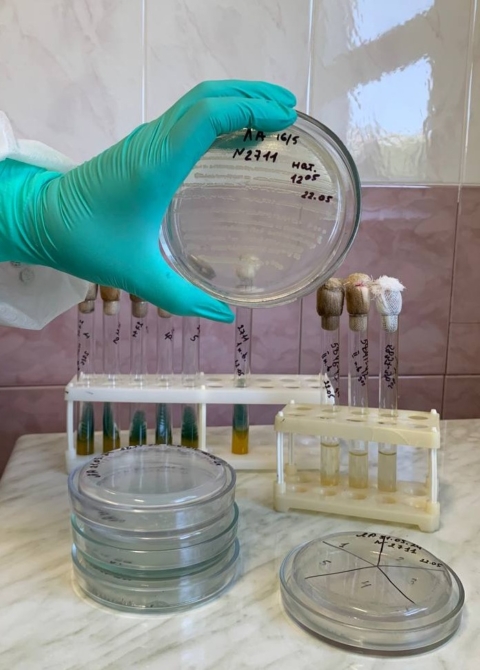

Тренувальні навчання з реагування на холеру відбулися в м. Чорноморськ
24 травня 202422 травня 2024 року в місті Чорноморськ пройшли масштабні тренувальні навчання на випадок виявлення холери. Захід був організований відповідно до спільного наказу ДУ «Одеський обласний центр контролю та профілактики хвороб МОЗ» та Департаменту охорони здоров’я Одеської обласної державної адміністрації № 03/СП/3-Од від 1 травня 2024 року. Навчання проводилися за заздалегідь підготовленим сценарієм, який імітував реальний випадок виявлення захворювання.
Сценарій навчань
Згідно з легендою, Моряк Р., мешканець Чорноморська, прибув до порту на т/х «Discover» 20 травня. 22 травня він звернувся за медичною допомогою до сімейного лікаря КНП «Чорноморський міський центр первинної медико-санітарної допомоги» зі скаргами на загальну слабкість, головний біль, дискомфорт та вирування в животі, діарею до 5-6 разів на добу та однократне блювання. Симптоми з’явилися в ніч з 21 на 22 травня.
Сімейний лікар організував прийом хворого в окремому спеціально облаштованому кабінеті, призначеному для прийому пацієнтів з ознаками інфекційних захворювань. Кабінет має окремий вхід, що дозволяє уникнути контакту з іншими пацієнтами.
Проведення тестування та госпіталізація
У спеціально облаштованому кабінеті пацієнту провели швидкий тест на холеру та відібрали проби для мікробіологічних і ПЛР-досліджень в лабораторії особливо небезпечних інфекцій (ОНІ). Після обробки кабінету та речей пацієнта проведено дезінфекцію. Хворого було доставлено до інфекційного відділення КНП «Чорноморська лікарня» бригадою екстреної медичної допомоги підстанції №8.
Дезінфекційні заходи
Наступним етапом навчань стала дезінфекція судна, на якому хворий прибув до Чорноморська, а також його житлового приміщення, особистого автомобіля та автомобіля швидкої допомоги. Епідеміологічна бригада санітарно-карантинного відділу (СКВ) провела медичний огляд екіпажу судна, відбір біоматеріалу для лабораторних досліджень на холеру та комплекс протиепідемічних заходів на судні. Судно було перешвартоване на карантинний причал та піддано поточній та заключній дезінфекції.
Учасники навчань
У навчаннях взяли участь фахівці з різних медичних установ, зокрема:
- ДУ «Одеський обласний центр контролю та профілактики хвороб МОЗ»
- КНП «Чорноморська лікарня»
- КНП «Чорноморський міський Центр первинної медико-санітарної допомоги»
- Підстанція екстреної медичної допомоги №8 КНП «Одеський обласний центр екстреної медичної допомоги і медицини катастроф»
Висновки та підсумки
Під час навчань фахівці продемонстрували поетапність надання медичної допомоги хворому з підозрою на холеру, починаючи від дій сімейного лікаря до госпіталізації хворого та проведення протиепідемічних заходів. Були відпрацьовані навички збору епіданамнезу, відбору проб для лабораторних досліджень, проведення дезінфекції, утилізації ЗІЗ та біологічних рідин, проведення швидких діагностичних тестів і досліджень ПЛР на холеру.
Після завершення навчань підведено підсумки та надано оцінку готовності медичних закладів до локалізації умовного вогнища карантинного захворювання. Навчання показали високий рівень готовності всіх залучених служб до реагування на випадок виявлення холери.